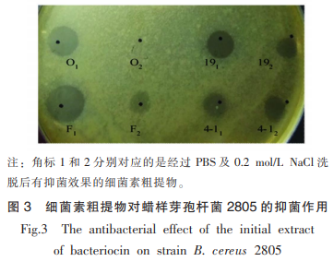

硫酸銨提取得到的細(xì)菌素粗提物對(duì)蠟樣芽孢桿菌有明顯的抑菌效果。用PBS和0.2mol/LNaCl溶液洗脫經(jīng)硫酸銨得到的細(xì)菌素粗提物并分別收集其洗脫液然后凍干。經(jīng)抑菌試驗(yàn)發(fā)現(xiàn)經(jīng)過PBS和0.2mol/LNaCl洗脫的組分可以較好地抑制蠟樣芽孢桿菌(圖3)。
圖4是產(chǎn)細(xì)菌素芽孢桿菌的Tricine-SDSPAGE電泳結(jié)果。由于Tricine-SDS-PAGE電泳可以較好地分離<30ku的蛋白,因此選用3.3~20.1ku的標(biāo)準(zhǔn)蛋白做對(duì)照。與Marker條帶對(duì)比可知菌株O在14.4ku左右時(shí)有一條較為明顯的條帶。菌株19在8ku和18ku處有明顯的蛋白條帶。菌株F則在8ku處、14.4ku左右均出現(xiàn)明顯的條帶。菌株4-1在14.4ku左右時(shí)有一條蛋白條帶。4株芽孢桿菌的Tricine-SDS-PAGE電泳結(jié)果可以初步判斷出其所產(chǎn)細(xì)菌素的分子質(zhì)量均小于20ku。該結(jié)果也表明這些菌株所產(chǎn)細(xì)菌素可能為熱穩(wěn)定性較好的II類小分子蛋白。

表4為產(chǎn)細(xì)菌素芽孢桿菌的LC-MS/MS鑒定結(jié)果。結(jié)合Tricine-SDS-PAGE電泳試驗(yàn)結(jié)果可以初步判斷菌株O所產(chǎn)細(xì)菌素可能為13ku大小的含有DUF1093結(jié)構(gòu)域的蛋白質(zhì)、13.506ku大小的YlbF家族監(jiān)管蛋白及18.877ku的1型谷氨酰胺轉(zhuǎn)移酶;菌株19產(chǎn)生的細(xì)菌素可能為8.969ku的假設(shè)蛋白CXF51_07005、16.871ku大小的SPBc2原噬菌體衍生的蛋白質(zhì)YolA以及18.001ku大小的假設(shè)蛋白BEST7613_2224;菌株F所產(chǎn)細(xì)菌素可能為分子質(zhì)量大小為8.089ku的假設(shè)蛋白C1T28_21195、13.011ku大小的降解酶(加氧酶)、15.786ku大小的holin家族蛋白質(zhì)以及分子質(zhì)量為17.082ku的SMI1/KNR4家族蛋白;菌株4-1產(chǎn)生的細(xì)菌素可能對(duì)應(yīng)為9.439ku的小分子質(zhì)量的酸溶性孢子蛋白Tlp或是分子質(zhì)量為22.529ku的3-己酮糖-6-磷酸合成酶。目前的結(jié)果與蛋白數(shù)據(jù)庫(kù)內(nèi)已編號(hào)的蛋白比較,沒有完全一致的蛋白相匹配,表明本研究中發(fā)現(xiàn)的細(xì)菌素不排除為新型細(xì)菌素的可能。細(xì)菌素進(jìn)一步純化,氨基酸序列比對(duì)和產(chǎn)細(xì)菌素的細(xì)菌全基因組序列進(jìn)行測(cè)序分析,從而準(zhǔn)確判斷這4株芽孢桿菌所產(chǎn)細(xì)菌素是否為新型細(xì)菌素。


本研究從福建牡蠣中分離篩選出14株對(duì)常見致病菌有抑菌活性的芽孢桿菌菌株,通過抑菌試驗(yàn)發(fā)現(xiàn)這些芽孢桿菌對(duì)金黃色葡萄球菌、蠟樣芽孢桿菌、植物乳桿菌等革蘭氏陽(yáng)性菌及弗氏檸檬酸桿菌、副溶血性弧菌、大腸桿菌、腸道沙門氏菌、志賀氏菌等革蘭氏陰性菌均有一定的抑菌作用。同時(shí),這些芽孢桿菌產(chǎn)的細(xì)菌素具有熱穩(wěn)定性強(qiáng)、易被蛋白酶分解和由核糖體編碼合成產(chǎn)生細(xì)菌素等典型細(xì)菌素特征。根據(jù)14株菌的抑菌譜范圍和rep-PCR結(jié)果,初步判斷4種菌株可能不同于其它芽孢桿菌。因此,選取這4株菌O(解淀粉芽孢桿菌),4-1(死亡谷芽孢桿菌),19和F(枯草芽孢桿菌)進(jìn)行下一步試驗(yàn)。通過Tricine-SDSPAGE電泳試驗(yàn),這4株芽孢桿菌產(chǎn)的細(xì)菌素分子質(zhì)量均不大于20ku。說明上述4株細(xì)菌可能產(chǎn)II類乳酸菌細(xì)菌素。利用LC-MS/MS鑒定并比對(duì)現(xiàn)有蛋白質(zhì)數(shù)據(jù)庫(kù),結(jié)果顯示這4株芽孢桿菌所產(chǎn)細(xì)菌素未在現(xiàn)有數(shù)據(jù)庫(kù)中發(fā)現(xiàn),細(xì)菌素進(jìn)一步純化,氨基酸序列比對(duì)和產(chǎn)細(xì)菌素的細(xì)菌全基因組序列進(jìn)行測(cè)序分析仍需在未來試驗(yàn)中進(jìn)行,從而準(zhǔn)確確定這4株芽孢桿菌的細(xì)菌素性質(zhì)。
聲明:本文所用圖片、文字來源《中國(guó)食品學(xué)報(bào)》,版權(quán)歸原作者所有。如涉及作品內(nèi)容、版權(quán)等問題,請(qǐng)與本網(wǎng)聯(lián)系
相關(guān)鏈接:大腸桿菌,蠟樣芽孢桿菌,谷氨酰胺,硫酸銨